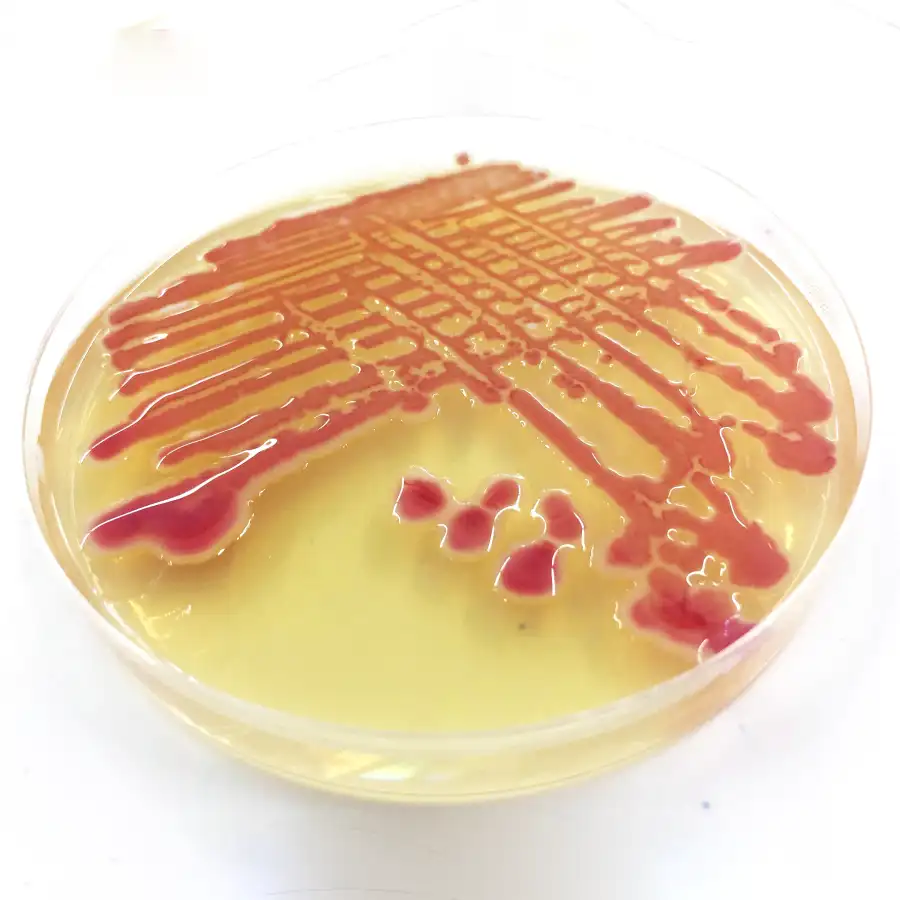

Bioensayos
Sustente los atributos de sus insumos con resultados medibles y acelere sus procesos de registro ante la autoridad competente.
Respaldo científico y cumplimiento normativo para el éxito comercial de sus productos.
Los bioensayos representan un soporte estratégico para empresas que desarrollan o comercializan insumos agrícolas, ya que permiten sustentar atributos de producto con resultados medibles y comparables frente a estándares del mercado. Además, generan información clave para procesos de registro, posicionamiento y diferenciación comercial, fortaleciendo argumentos de venta con respaldo técnico y facilitando la comunicación de beneficios al mercado.
Contar con bioensayos bien diseñados y ejecutados no solo permite cumplir con los requisitos regulatorios para el registro y comercialización, sino que también acelera los procesos de aprobación y reduce observaciones por parte de la autoridad competente. En consecuencia, se convierten en una inversión estratégica que conecta el desarrollo técnico con el éxito comercial, asegurando que los productos lleguen al mercado con respaldo científico sólido y cumplimiento normativo.